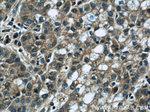
DEPDC6/Deptor Antibody in Immunohistochemistry (Paraffin) (IHC (P))

Search
Proteintech
DEPDC6/Deptor Polyclonal Antibody
{{$productOrderCtrl.translations['antibody.pdp.commerceCard.promotion.promotions']}}
{{$productOrderCtrl.translations['antibody.pdp.commerceCard.promotion.viewpromo']}}
{{$productOrderCtrl.translations['antibody.pdp.commerceCard.promotion.promocode']}}: {{promo.promoCode}} {{promo.promoTitle}} {{promo.promoDescription}}. {{$productOrderCtrl.translations['antibody.pdp.commerceCard.promotion.learnmore']}}
产品信息
20985-1-AP
种属反应
已发表种属
宿主/亚型
分类
类型
抗原
偶联物
形式
浓度
规格
纯化类型
保存液
内含物
保存条件
运输条件
产品详细信息
The antibody is specific to DEPDC6.
靶标信息
DEPDC6 is a gene that encodes a protein known for its role in various cellular processes, although the specifics of its function remain not fully elucidated. Located on chromosome 22, DEPDC6 is involved in regulating cell growth and survival by modulating the RAS signaling pathway, a crucial pathway for many cellular functions. Structurally, DEPDC6 contains a DEP domain, which is known to mediate interactions with other proteins that are involved in signal transduction. This domain plays a significant role in facilitating the proper localization and function of the protein. Functionally, DEPDC6 is implicated in controlling the pathways that govern the timing and progression of the cell cycle, highlighting its importance in maintaining cellular homeostasis and preventing uncontrolled cell proliferation. Its dysregulation has been associated with various cancers, emphasizing the need for further studies to fully understand its potential as a therapeutic target.
仅用于科研。不用于诊断过程。未经明确授权不得转售。
生物信息学
蛋白别名: DEP domain containing 6; DEP domain containing MTOR-interacting protein; DEP domain-containing mTOR-interacting protein; DEP domain-containing protein 6; hDEPTOR; unnamed protein product
基因别名: DEP.6; DEPDC6; DEPTOR; hDEPTOR; Kiaa4200; RGD1561030
UniProt ID: (Human) Q8TB45, (Mouse) Q570Y9
Entrez Gene ID: (Human) 64798, (Mouse) 97998, (Rat) 314979